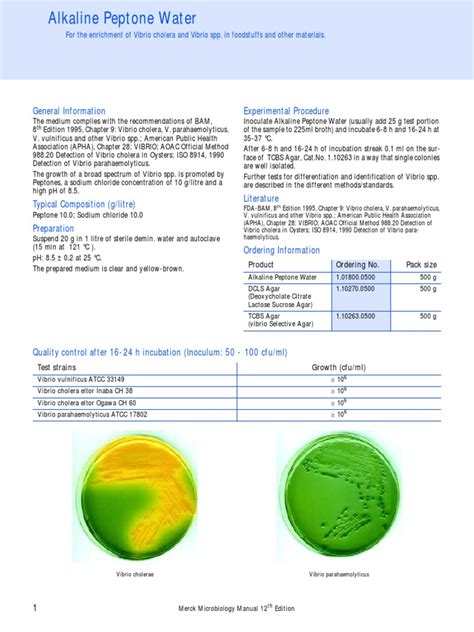

Alkaline Peptone Water: A Simple Guide
Alkaline Peptone Water: Your Go-To for Microbial Testing
Hey everyone! Today, we’re diving deep into a topic that might sound a bit technical, but trust me, it’s super important in the world of microbiology and food safety: Alkaline Peptone Water (APW) . You’ve probably heard the term, maybe seen it in a lab setting, or even wondered what it’s all about. Well, you’ve come to the right place! We’re going to break down what APW is, why it’s so darn useful, and how it plays a crucial role in ensuring the safety of our food and water. So grab a coffee, settle in, and let’s get this show on the road!
Table of Contents
What Exactly is Alkaline Peptone Water?
Alright, first things first, let’s get a handle on what we’re even talking about. Alkaline Peptone Water is essentially a type of growth medium, a special broth used primarily in microbiology labs. Think of it as a nutrient-rich soup designed to encourage the growth of specific types of bacteria. The ‘alkaline’ part isn’t just for show; it means the solution has a pH level higher than 7, making it a bit basic. This specific pH is key because it favors the growth of certain bacteria, most notably Vibrio species. You know, those guys that can sometimes be found in seafood and can cause health issues if not handled properly? Yeah, APW is often the first step in detecting them. The ‘peptone’ comes from the breakdown of proteins, providing essential amino acids and peptides that bacteria love to munch on. So, in a nutshell, it’s a slightly alkaline, nutrient-rich liquid concoction that’s a favorite hangout spot for particular microorganisms, making them easier for scientists to find and identify. Pretty neat, huh?
Why is APW So Important?
The importance of Alkaline Peptone Water can’t be overstated, especially when we talk about public health and safety. Its primary role is as a selective enrichment medium. What does that even mean, you ask? It means APW is designed to give a head start to the bacteria we’re looking for, while making it a bit tougher for other, less interesting or potentially interfering microbes to thrive. This selectivity is a game-changer in analyzing samples from, say, seafood, water, or even clinical specimens. Imagine trying to find a needle in a haystack; APW helps make that needle a bit brighter and the haystack a bit sparser. By providing an environment where Vibrio and similar bacteria can multiply rapidly, APW increases their numbers significantly. This makes them much easier to detect using subsequent testing methods, like plating on specific agar or using molecular techniques. Without APW, detecting low levels of these potentially harmful bacteria would be incredibly difficult, if not impossible, leading to a much higher risk of contamination going unnoticed. It’s a critical tool in the arsenal for food and waterborne illness prevention, helping regulatory agencies and food producers maintain high standards and protect consumers from nasty bugs. Seriously, it’s a silent guardian of our health!
How is APW Made and Used?
Let’s talk about how this magical broth is actually put together and what happens in the lab. Making Alkaline Peptone Water is relatively straightforward, which is another reason it’s so widely used. The standard recipe typically involves dissolving peptone (like proteose peptone or soytone) and sodium chloride (that’s just good old salt, guys!) in distilled water. The key ingredient, though, is the alkali. Usually, sodium hydroxide (NaOH) is added to adjust the pH to a specific alkaline level, typically around 8.0 to 8.5. It’s crucial to get this pH just right, as it’s the secret sauce that favors the target bacteria. Once prepared, the APW is sterilized, usually by autoclaving, to ensure no unwanted microbes are already hanging out in the broth. Then comes the exciting part: using it! A sample suspected of containing the target bacteria (like a swab from a food processing surface or a water sample) is added to a tube or flask of APW. This mixture is then incubated, usually at a warm temperature like 35-37°C, for a specific period, often 18-24 hours. During incubation, the target bacteria, if present, will multiply. After incubation, a loopful of this enriched broth is transferred to selective agar plates for further identification and quantification. It’s a crucial pre-enrichment step that boosts the chances of successful detection. Pretty straightforward, right? It’s a simple process with profound implications for safety.
The Science Behind the Alkalinity
Now, let’s geek out a little on why the alkaline pH is so vital. The Alkaline Peptone Water works its magic because different bacteria have different preferences for their environment, kind of like how you might prefer a warm beach over a snowy mountain. Many common bacteria found in everyday environments, like E. coli or Salmonella , tend to prefer a more neutral pH, closer to what we consider normal. However, bacteria like Vibrio parahaemolyticus and Vibrio cholerae , which are often associated with marine environments and can cause food poisoning, actually thrive in a more alkaline setting. By adjusting the pH of the peptone water to 8.0-8.5, we’re essentially creating a VIP lounge for these Vibrio species. Other bacteria that might compete with them for nutrients or interfere with detection methods find this environment less hospitable. This selective pressure means that even if the initial sample has only a few Vibrio cells among millions of other bacteria, the APW will allow the Vibrio to outcompete and multiply, making them detectable in the next stage of testing. It’s a clever bit of microbiology that leverages the specific physiological needs of different organisms to simplify the detection process. This pH preference is a fundamental characteristic that makes APW such an effective tool for its intended purpose.
Common Applications of APW
So, where exactly do we see Alkaline Peptone Water being put to work? Its applications are pretty widespread, particularly in industries where microbial contamination is a serious concern. The most common use, as we’ve touched upon, is in the food industry , especially for testing seafood products like fish, shrimp, and oysters. These are often harvested from marine environments where Vibrio bacteria naturally occur, so ensuring they are safe for consumption is paramount. APW is used as the initial enrichment step to detect the presence of Vibrio species before they can cause illness. Beyond seafood, APW can also be used to test water samples , including recreational waters, drinking water sources, and wastewater, to monitor for potential Vibrio contamination. In a clinical setting, though less common than in food testing, APW might be employed in the microbiological examination of certain clinical samples where Vibrio infections are suspected. It’s also a staple in research laboratories studying the physiology and ecology of Vibrio bacteria or developing new detection methods. Essentially, any situation where a sensitive detection of Vibrio or other alkali-tolerant bacteria is required is a prime candidate for using APW. It’s a versatile tool that plays a critical role in public health surveillance and quality control across various sectors.
Advantages and Limitations
Like any scientific tool, Alkaline Peptone Water has its own set of pros and cons. Let’s start with the good stuff. One of the biggest advantages is its simplicity and cost-effectiveness . The ingredients are readily available and relatively inexpensive, and the preparation is straightforward, making it accessible to most laboratories. It’s also highly effective as a pre-enrichment medium for Vibrio species, significantly increasing the chances of detecting low levels of contamination. Its alkaline pH provides a degree of selectivity , helping to suppress the growth of competing microflora. However, APW isn’t perfect. Its main limitation is that it’s not completely specific . While it favors Vibrio , other alkali-tolerant bacteria might also grow, potentially leading to false positives if subsequent identification steps aren’t thorough. Furthermore, APW is just the first step. It enriches the bacteria, but it doesn’t identify or quantify them on its own. You still need to follow up with selective plating and other diagnostic tests. Also, improper preparation, especially incorrect pH adjustment or sterilization, can render the medium ineffective or even introduce contaminants. So, while it’s a fantastic tool, it requires careful handling and should always be used as part of a comprehensive testing protocol. Knowing these trade-offs helps us use APW effectively and interpret the results correctly.
The Future of APW and Microbial Detection
While Alkaline Peptone Water has been a workhorse in microbiology for a long time, the field of microbial detection is constantly evolving. You might be wondering if APW is going to be replaced by newer, fancier technologies. The truth is, APW is likely to stick around for quite a while, especially for its established role in Vibrio detection due to its cost-effectiveness and simplicity. However, we are seeing exciting advancements that complement or, in some cases, offer alternatives to traditional methods. Think about molecular techniques , like PCR (polymerase chain reaction), which can detect the DNA of specific bacteria very quickly and sensitively, often without the need for enrichment. Immunoassays that use antibodies to detect bacterial antigens are also becoming more sophisticated. Biosensors and lab-on-a-chip devices promise even faster, on-site detection. These newer technologies often offer speed and higher specificity. Yet, they can sometimes be more expensive or require specialized equipment and expertise. For routine screening, especially in resource-limited settings, the reliability and low cost of APW make it hard to beat. The future likely involves a hybrid approach , where APW continues to be used for initial enrichment, perhaps followed by rapid molecular confirmation, or where newer methods are adopted based on specific needs for speed, sensitivity, or cost. It’s all about using the right tool for the job, and APW certainly remains a valuable tool in our microbial detection toolbox, guys!
So there you have it, a deep dive into Alkaline Peptone Water! It’s a simple yet powerful tool that plays a vital role in keeping our food and water safe. Understanding its purpose and how it works is key to appreciating the intricate science behind everyday safety measures. Keep exploring, keep learning, and stay curious!